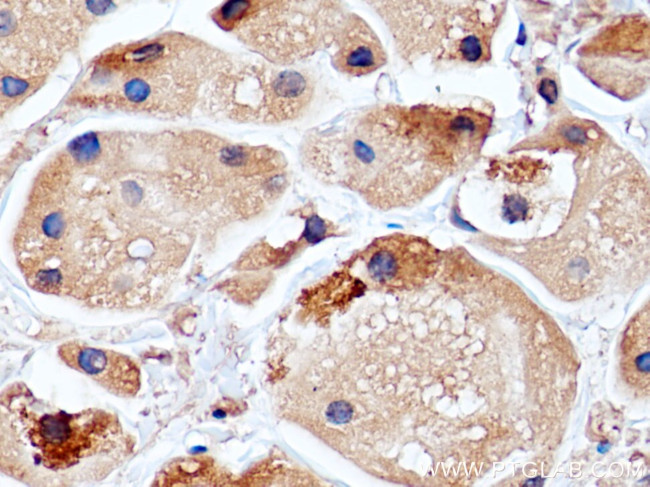
RCAS1 Antibody in Immunohistochemistry (Paraffin) (IHC (P))

Search
Proteintech
RCAS1 Monoclonal Antibody (4H8A12)
{{$productOrderCtrl.translations['antibody.pdp.commerceCard.promotion.promotions']}}
{{$productOrderCtrl.translations['antibody.pdp.commerceCard.promotion.viewpromo']}}
{{$productOrderCtrl.translations['antibody.pdp.commerceCard.promotion.promocode']}}: {{promo.promoCode}} {{promo.promoTitle}} {{promo.promoDescription}}. {{$productOrderCtrl.translations['antibody.pdp.commerceCard.promotion.learnmore']}}
产品信息
66170-1-IG
宿主/亚型
分类
类型
克隆号
抗原
偶联物
形式
浓度
规格
保存条件
运输条件
产品详细信息
Immunogen sequence: MAITQFRLF KFCTCLATVF SFLKRLICRS GRGRKLSGDQ ITLPTTVDYS SVPKQTDVEE WTSWDEDAPT SVKIEGGNGN VATQQNSLEQ LEPDYFKDMT PTIRKTQKIV IKKREPLNFG IPDGSTGFSS RLAATQDLPF IHQSSELGDL DTWQENTNAW EEEEDAAWQA EEVLRQQKLA DREKRAAEQQ RKKMEKEAQR LMKKEQNKIG VKLS (1-213 aa encoded by BC017729)
靶标信息
This gene was identified as an estrogen-responsive gene. Regulation of transcription by estrogen is mediated by estrogen receptor which binds to the estrogen-responsive element found in the 5'-flanking region of this gene. The encoded protein is a tumor-associated antigen that is expressed at high frequency in a variety of cancers. Two transcript variants differing in the 5' UTR, but encoding the same protein, have been identified for this gene.
仅用于科研。不用于诊断过程。未经明确授权不得转售。